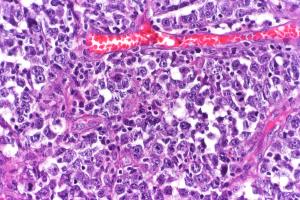

This review article discusses which frontline treatment are best for diffuse large B-cell lymphoma.
Your AI-Trained Oncology Knowledge Connection!
This review article discusses which frontline treatment are best for diffuse large B-cell lymphoma.
By combining the most recent medical literature and expert opinion, this revised guideline can aid clinicians in the complex decision-making associated with the management of recurrent Hodgkin lymphoma.
Although the cure rate remains high in women who present with bulky mediastinal stage I–II HL, the challenge remains to balance efficacy and minimize long-term toxicities.
The present guidelines review epidemiology, pathology, presentation, workup, staging, prognostic factors, and treatment options for patients with localized nodal indolent lymphoma, with an emphasis on radiation guidelines, including radiation dose, field design, and radiation techniques.
Published: January 20th 2022 | Updated:
Published: March 16th 2014 | Updated:
Published: August 15th 2013 | Updated:
Published: December 15th 2016 | Updated: